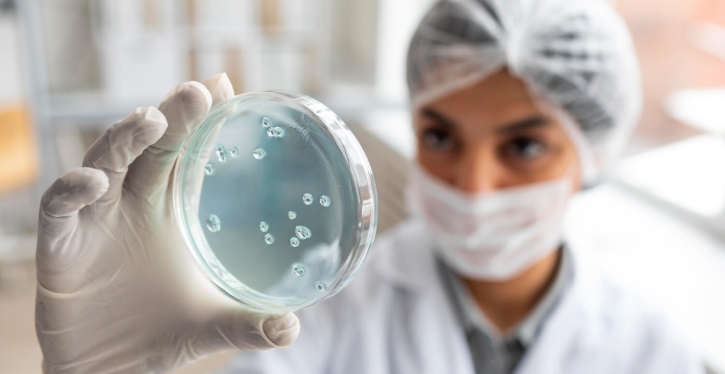
A falta de sanitização dos reservatórios pode provocar a proliferação de bactérias na água

Colapso de prédio em Florianópolis é um alerta para síndicos
23/01/2024 -
Plano de contingência para realizar uma estabilização emergencial da edificação está em execução
GARANTIA
Exigir ART é uma garantia para o síndico
08/11/2023 -
A exigência da Anotação de Responsabilidade Técnica (ART) é uma garantia de qualidade profissional e protege legalmente o síndico caso ocorra qualquer imprevisto
SEGURANÇA
Vazamento de gás é um risco que pode ser evitado
08/09/2023 - Fabiane Berlese
A distribuição de gás no condomínio é uma operação segura, mas a manutenção deve estar em dia
PREVENÇÃO
Seu prédio está preparado para os eventos climáticos?
24/08/2023 - Dariane Campos
Com a previsão do fenômeno El Niño atuando no país, especialistas afirmam que a prevenção é a principal medida capaz de “blindar” o seu condomínio
PRAZOS
Piscinas limpas no inverno
17/08/2023 -
Mesmo na baixa temporada, os prazos para a limpeza devem ser obedecidos
PERIGO
O que fazer em caso de incêndio em condomínio?
11/08/2023 - Jorge Oliveira
Não utilizar elevadores em ocorrências de fogo é uma das recomendações dos Bombeiros
PLANEJAMENTO
Os processos para uma gestão eficiente de obras de grande porte em condomínios
09/08/2023 -
Demanda por melhorias em edifícios exige esforço dos síndicos para cumprir metas de planejamento, organização e acompanhamento da obra
SEGURANÇA
Inspeção predial garante vida longa ao imóvel e previne acidentes
11/05/2023 - Dariane Campos
Manter o patrimônio imobiliário em boas condições de conservação já faz parte da cultura de muitos países desenvolvidos. Por isso, engana-se quem pensa que para ter um imóvel duradouro basta apenas um bom projeto e qualidade na execução da obra.
HIGIENIZAÇÃO
Como está a qualidade da água no seu condomínio?
08/05/2023 - Dariane Campos
Celebrado no dia 22 de março, o Dia Mundial da Água é uma data importante para lembrar a importância desse recurso para a manutenção da vida humana, das plantas e dos animais e, sobretudo, para garantir que todos tenham acesso a água de qualidade e que atenda aos padrões de potabilidade estabelecidos pelos órgãos de saúde.
CORPO DE BOMBEIROS
Pressurização de escadas aumenta segurança nos edifícios em casos de incêndio
19/04/2023 -
Quase 200 prédios de Balneário Camboríu possuem o sistema que segue a Instrução Normativa nº 9 do Corpo de Bombeiros Militar de Santa Catarina
Está procurando Fornecedores?
Aqui você encontra
Copyright © 2026 CondomínioSC
Todos os direitos protegidos e reservados | Faça contato com a Redação
Todos os direitos protegidos e reservados | Faça contato com a Redação